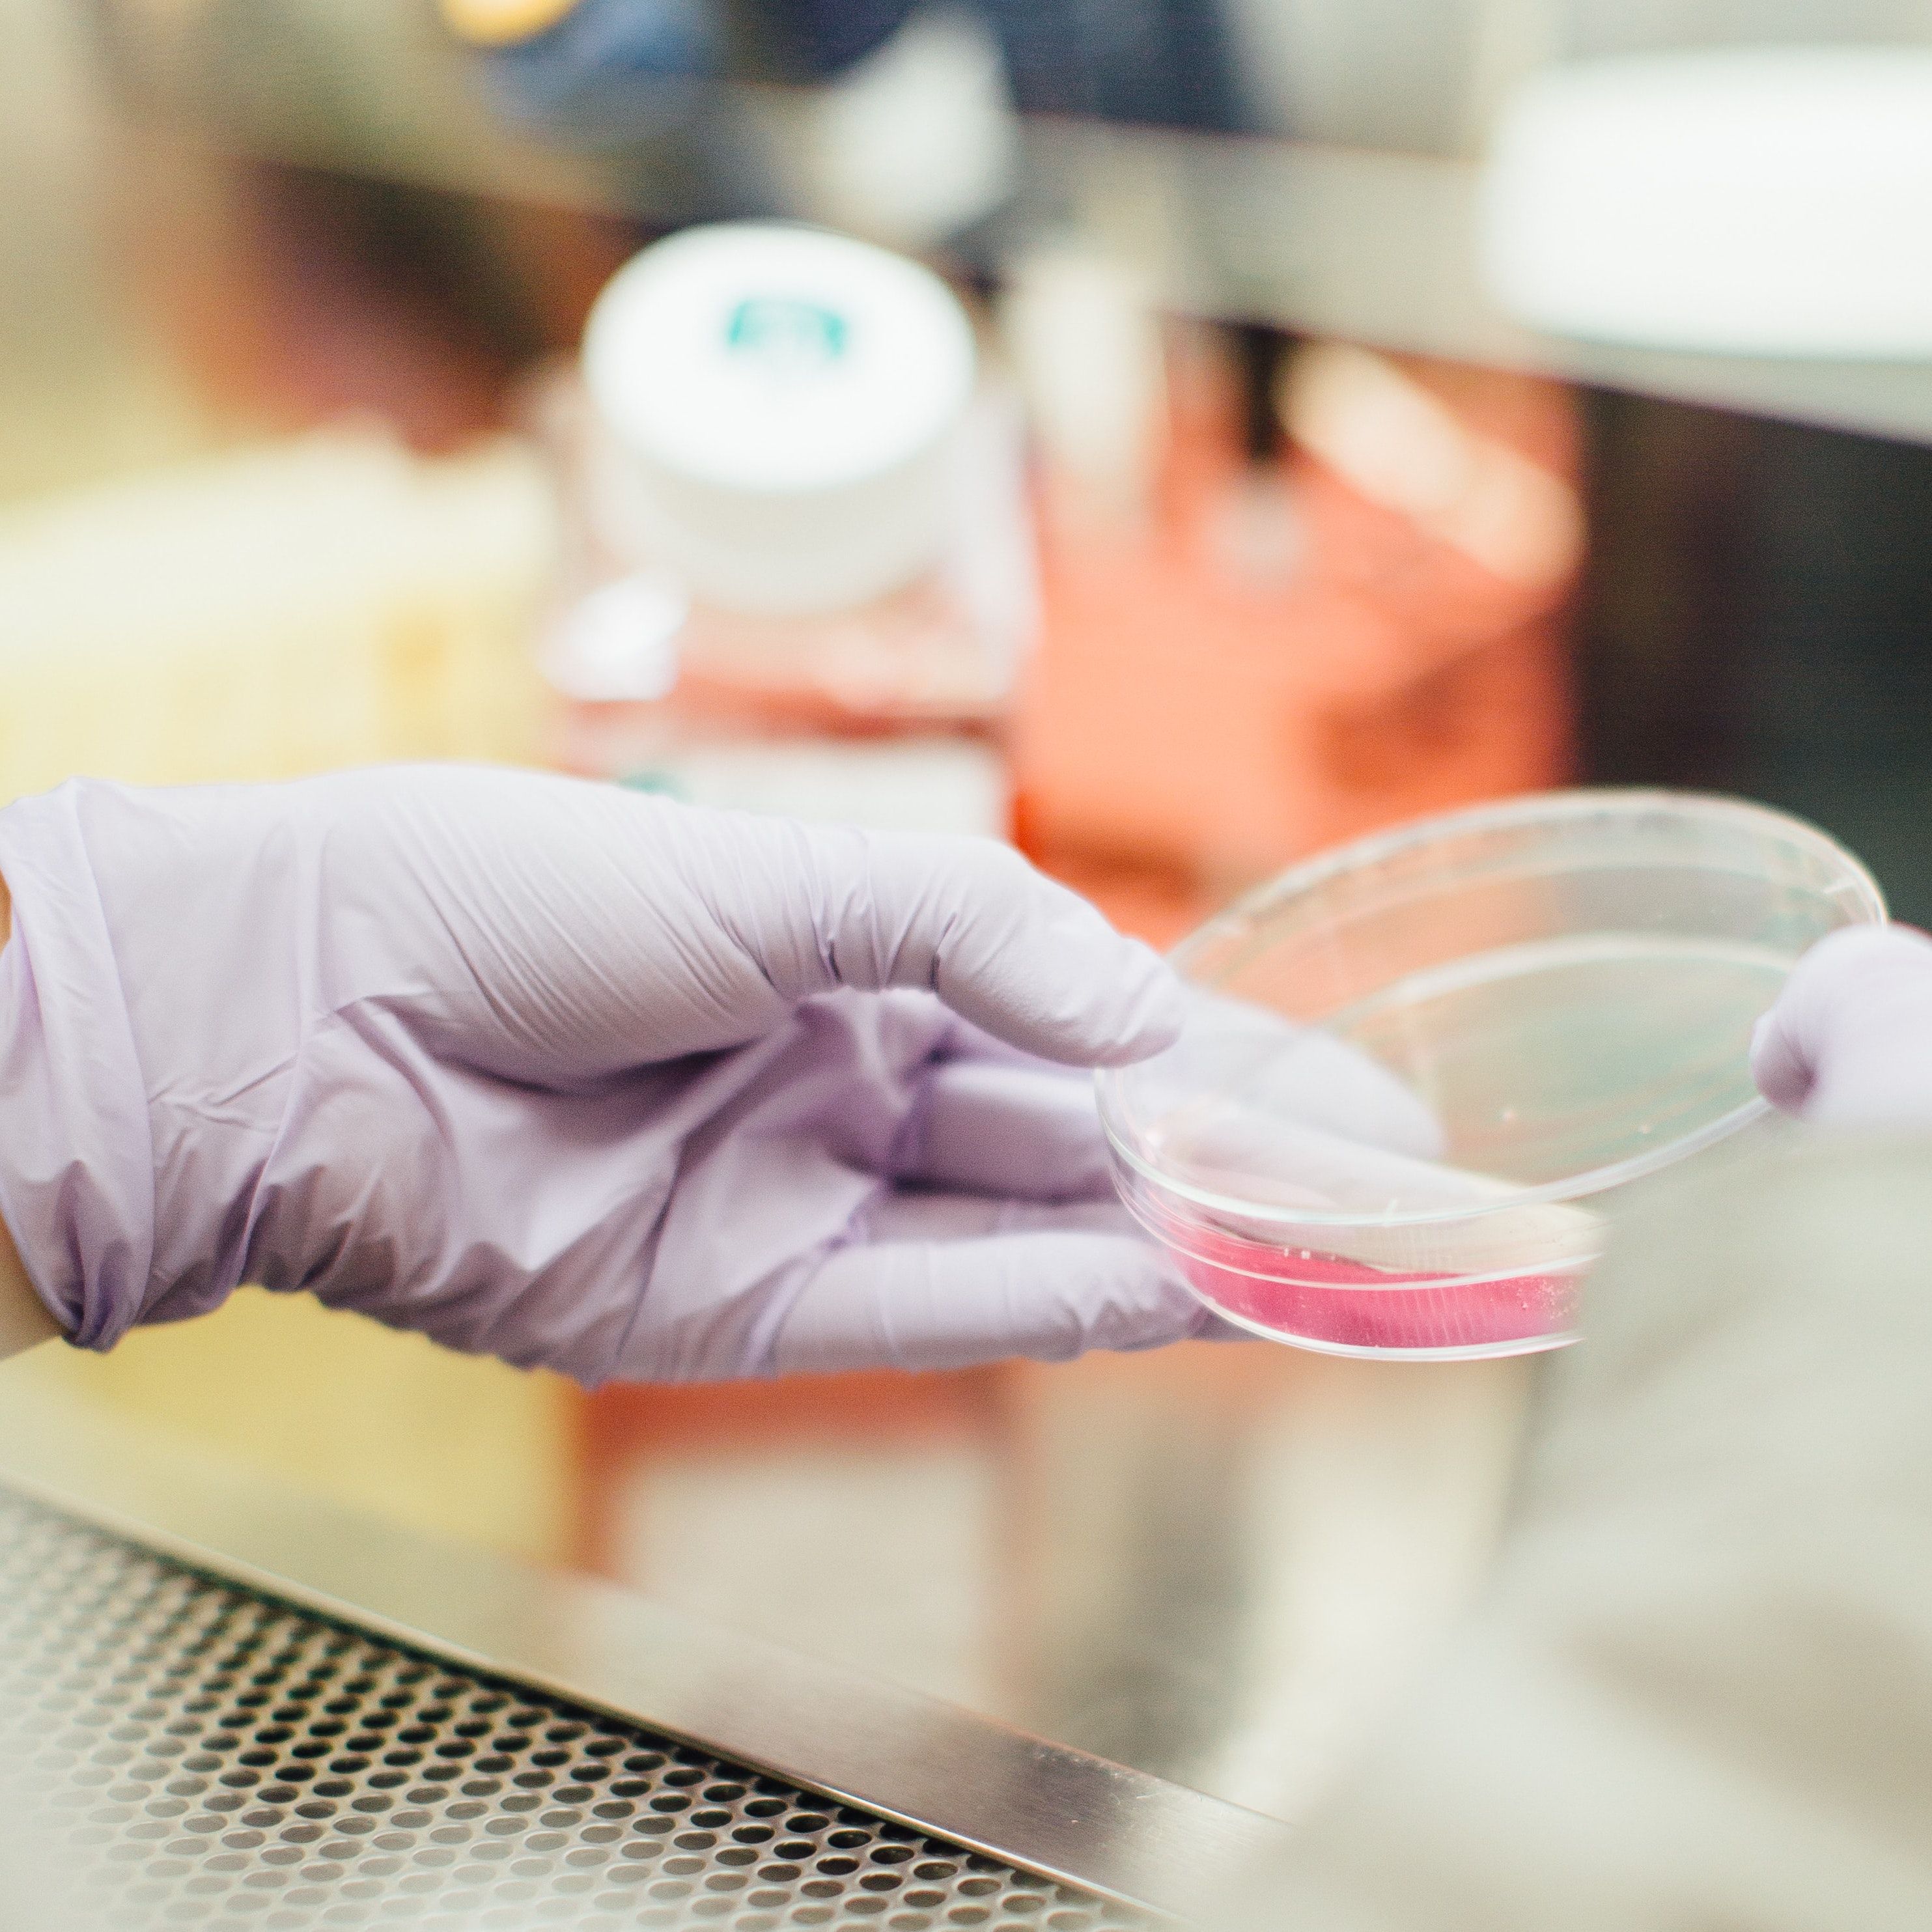

19+ How To Say Metoprolol
Web The brand name Lopressor is pronounced. Metoprolol tartrate brand name Lopressor is a B1-selective blocker.

Covid 19 Msd
Mix the contents of the opened capsule.

. Web How to Pronounce Metoprolol Succinate in American English Correctly Pronunciation World 685 subscribers Subscribe 0 Share 6 views 6 days ago How do you pronounce. Web metoprolol noun met o pro lol me-ˈtō-prə-ˌlȯl -ˌlōl. Web 15 hours agoA new scientific review suggests that mask mandates per the CDCs recommendations may have done little to nothing to curb the transmission of COVID.
Web Metoprolol is in a class of medications called beta blockers. Web House Freedom Caucus lawmakers taking a hard line against raising the US. It is given to people who have already had a heart attack.
Two different salts are available. Governments 314 trillion debt ceiling rely heavily on small donors to fund their. Web Metoprolol is a selective beta-blocker at dosages usually prescribed to lower blood pressure or relieve the symptoms of angina.
It works by relaxing blood vessels and slowing heart rate to improve blood flow and decrease blood pressure. You may also use a nasogastric tube to give the medicine. Your browser does not support the audio element.
A beta-blocker C15H25NO3 used in the form of its succinate and tartrate especially to treat hypertension and angina pectoris. Web Metoprolol is also used to treat severe chest pain angina and lowers the risk of repeated heart attacks. Web Swallow the mixture within 60 minutes.
Do not store for later use.

Frontiers Work Life Balance Of The Employed Population During The Emergency Situation Of Covid 19 In Latvia

How To Pronounce Metoprolol Succinate Howtopronounce Com

Metoprolol Tartrate Vs Metoprolol Succinate Differences Similarities And Which Is Better

How To Pronounce Metoprolol Howtopronounce Com

Rtbpd2asaufk7m

Playing The Blame Game The Uphill Battle To Prevent College Partying Npr

Covid 19 Is Wrecking Our Sleep With Coronasomnia Tips To Fight Back
Pcr Test Can Detect Differentiate Sars Cov 2 Influenza A And B Rsv

Lake Murray Is It For The Next Bass World Championship Wltx Com

Penn Hills School District

How To Pronounce Metoprolol Memorizing Pharmacology Extended Explanation Youtube

Lake Edisto Park In Orangeburg County Now Open To The Public Wltx Com
/cloudfront-us-east-2.images.arcpublishing.com/reuters/6ACVQUORZZPCXICI2A3HFG7BNM.jpg)
China Health App Starts Online Sales Of Pfizer S Paxlovid For Covid Treatment Reuters

Covid 19 Information Hub

Who Health Alert Brings Covid 19 Facts To Billions Via Whatsapp

The Major Genetic Risk Factor For Severe Covid 19 Is Inherited From Neanderthals Nature

Myocarditis Covid 19 Is A Much Bigger Risk To The Heart Than Vaccination